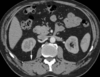
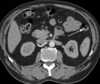

Abdomen Flashcards
(86 cards)
1
Q

A
falciform ligament
2
Q

A
middle hepatic vein
3
Q

A
common bile duct
4
Q

A
superior mesenteric artery
5
Q

A
left hepatic duct
6
Q

A
appendix
7
Q

A
segment 3 of liver
8
Q

A
superior mesenteric artery
9
Q

A
gastric antrum
10
Q
A
coeliac axis
11
Q

A
splenic flexure
12
Q

A
pancreas
13
Q

A
superior mesenteric artery
14
Q

A
portal vein
15
Q

A
right renal artery
16
Q

A
segment VIII of the liver
17
Q

A
left hepatic vein
18
Q

A
gallbladder wall
(<3mm thick)
19
Q

A
lesser curvature of the stomach
20
Q

A
left lower pole renal calyx
21
Q

A
left renal pelvis
22
Q

A
pancreatic duct
23
Q

A
2nd part of duodenum
24
Q

A
ileal branch of the SMA
25

common bile duct
26

splenic vein
27

common hepatic artery
28

portal vein
29

left hepatic duct
30

right hepatic vein
31

CBD
32

gastroduodenal artery
33
34

jejunal branches of the SMA
35

3rd part of the duodenum
36

2nd part of duodenum
37

common bile duct
38

posterior branch of the right portal vein
39
right quadratus lumborum
40

head of pancreas
41

head of pancreas
42

fundus of stomach
43

caecum
44

common hepatic artery
45

coeliac artery
aka coeliac axis
aka coeliac trunk
46

portal vein
47

right adrenal gland
48

pancreatic duct
49

3rd part of duodenum
50

hepatic artery proper
continuation of common hepatic artery after GDA given off
51

left hepatic artery
52

inferior vena cava
53

caecal pole
54

sigmoid colon
55

splenic vein
56

D3 of duodenum
57

portal vein
58

jejenum
59

left renal vein
60

cystic duct
61

left hepatic duct
62

right renal medullary pyramid
63

SMA
64

left proximal ureter
65

left hepatic duct
66

duodenal bulb
aka 1st part of duodenum
67

head of the pancreas
68

pylorus of stomach
69

SMA
70

jejenum
71

sartorius muscle
72

neck of the pancreas
73

ileocolic artery
74
75

left sided IVC
76

ileocolic artery
77

left transversus abdominis
78

Marginal artery of Drummond
(along border of the colon due to anastamoses of terminal branches of SMA and IMA)
79

incisura angularis
small anatomical notch on the stomach located on the lesser curvature of the stomach near the pyloric end
80

gastroduodenal artery
81

fat in the renal sinus
82

splenic artery
83
descending colon
84

ileum
85

proximal right ureter
86

segment VI of the liver